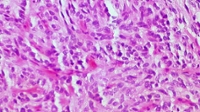

Nieuws
-
 Start van LUMC-Campus Den Haag18 maart 2016
Start van LUMC-Campus Den Haag18 maart 2016De LUMC-Campus Den Haag gaat met onderzoek, onderwijs en een huisartsenopleiding bijdragen aan de gezondheid van de inwoners van Den Haag. De nieuwe c...
-
 Masterdag trekt studenten uit alle windstreken14 maart 2016
Masterdag trekt studenten uit alle windstreken14 maart 2016Een jonge vluchteling die iets wil terugdoen voor Nederland, een Griekse die gaat studeren in het land van haar moeder en natuurlijk heel veel Nederla...
-
 5 cijfers over de Open Dag van 5 maart01 maart 2016
5 cijfers over de Open Dag van 5 maart01 maart 2016Duizenden nieuwsgierige studiezoekers en ouders bezoeken op 5 maart de Open Dag. Hoe krijgen ze snel een goed beeld van de studies én de stad?
-
 Oefenlab voor scholing en training van professionals en studenten in bedrijf09 februari 2016
Oefenlab voor scholing en training van professionals en studenten in bedrijf09 februari 2016De Biotech Training Facility (BTF) in het Leidse Bio Science Park is officieel in bedrijf genomen. In dit volledig geoutilleerde trainingscentrum met ...
-
Grote EU-subsidie voor innovatieve kankertherapie03 februari 2016
Grote EU-subsidie voor innovatieve kankertherapie03 februari 2016Het LUMC ontvangt ruim 4 miljoen euro subsidie om de komende 3 jaar een groot Europees onderzoek naar een vernieuwende behandeling van kanker te leiden.
-
 Ondernemende studenten met hart voor de maatschappij02 februari 2016
Ondernemende studenten met hart voor de maatschappij02 februari 2016Studenten van de minor Innovation, Cocreation and Global Impact presenteren hun idealistische projecten. Bekijk de film!
-
 LUMC biedt gratis online cursus over transplantatie08 januari 2016
LUMC biedt gratis online cursus over transplantatie08 januari 2016Als eerste medische instelling ter wereld biedt het LUMC een massive open online course (MOOC) over klinische nier- en pancreastransplantaties.
-
 ‘Als ex-vluchteling wil ik graag iets terugdoen’21 december 2015
‘Als ex-vluchteling wil ik graag iets terugdoen’21 december 2015De Afghaanse Niloufar Rahim vluchtte met haar familie naar Nederland. Ze studeerde geneeskunde in Leiden en traint nu studenten in Afghanistan.
-
 Ionica Smeets presenteert Nationale Wetenschapsquiz11 december 2015
Ionica Smeets presenteert Nationale Wetenschapsquiz11 december 2015Hoe krijgen spionnen in azijn gedrenkte eierschalen weer hard? Op kerstavond onthult hoogleraar wetenschapscommunicatie Ionica Smeets het antwoord op ...
-
 Met nieuwe inzichten terug naar Kabul07 december 2015
Met nieuwe inzichten terug naar Kabul07 december 2015Voor het eerst met patiënten praten en leren van een snijsessie op een lijk. Afghaanse geneeskundestudenten studeerden in Leiden dankzij de lustrumact...
-
‘Een fout antwoord bedenken, dát is pas moeilijk’30 oktober 2015
Het ging over multiple choice, over onderzoek naar onderwijs, over werkdruk en nog veel meer. Op 29 oktober werden in de Faculty Club vier nieuwe gepa...
-
Minister keurt aanvraag Leidse masteropleiding Farmacie goed02 september 2015
Minister van Onderwijs, Cultuur en Wetenschap Jet Bussemaker heeft de aanvraag voor de masteropleiding Farmacie in Leiden goedgekeurd. Een belangrijke...
-
 De Universiteit Leiden, het LUMC en Technion Universiteit (Haifa, Israël) slaan handen ineen17 januari 2014
De Universiteit Leiden, het LUMC en Technion Universiteit (Haifa, Israël) slaan handen ineen17 januari 2014Het Leids Universitair Medisch Centrum (LUMC), de Faculteit der Wiskunde en Natuurwetenschappen (W&N) van de Universiteit Leiden en de Israëlische Tec...
